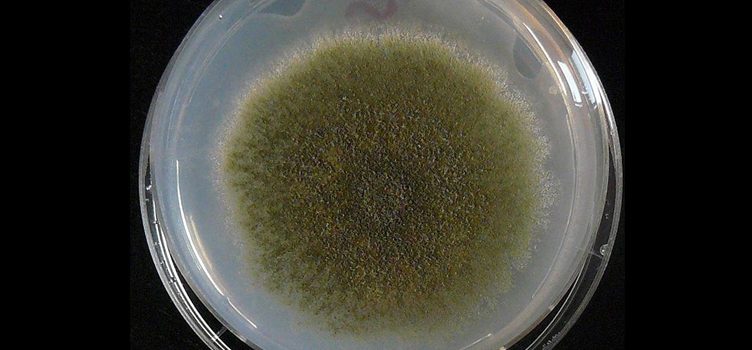

Bắn hạt neutrino với tốc độ gần bằng ánh sáng ở 1300km dưới lòng đất để nghiên cứu vật chất
- Tháng tư 6, 2016
- By:admin
- Category:Tin tức
- 0 comment
Các nhà khoa học Mỹ sắp tiến hành thử nghiệm bắn một chùm proton với vận tốc gần bằng ánh sáng đi xuyên qua 1300 km đất đá bên dưới mặt đất nhằm nghiên cứu " hạt ma" Neutrino. Các nhà khoa học Mỹ sắp tiến hành thử nghiệm bắn một chùm proton với vận tốc gần bằng ánh sáng…